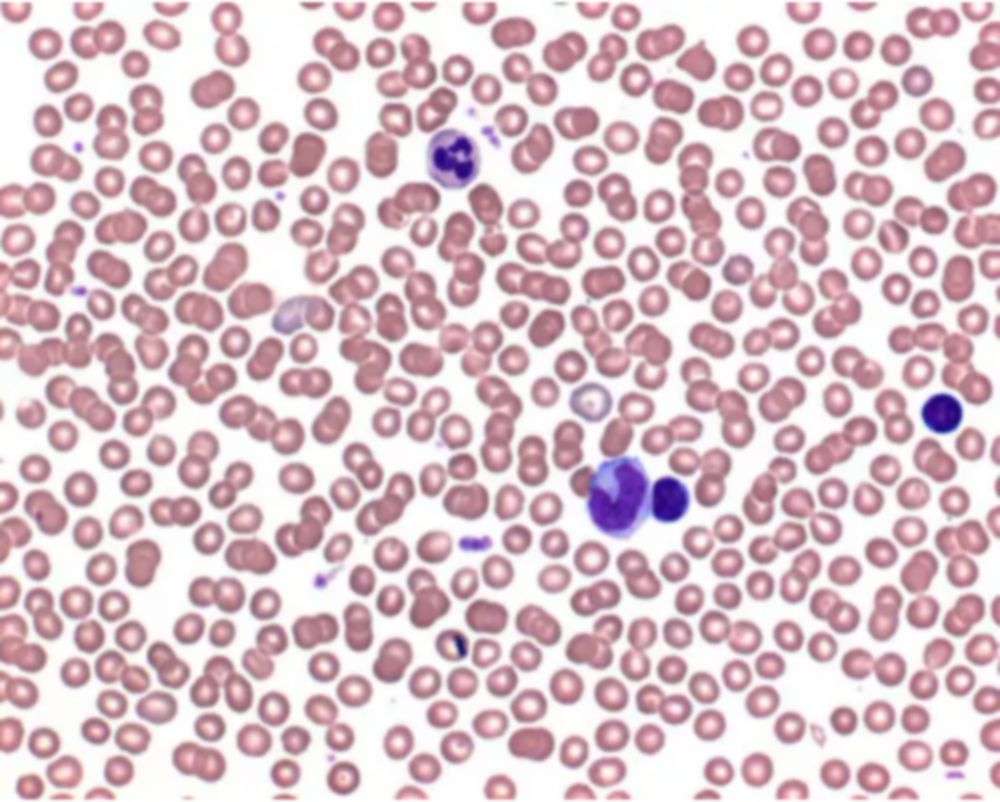
Buffertabletten ph 6,8   voor  bereiding bufferopl. vlg weis

Mojonnierkolf rond reservoir vlg DIN, l=187mm, Ø hals 13mm
Artikelnummer:
400-2
Lorenz
€ 30,40
Inhoud:
1ST
Levertijd: 6 weken of meer
🧑🔬 Al 130 jaar kennis en ervaring
⭐ Beoordeeld door klanten met een 7,9
👩💻 Persoonlijke aanpak met vaste contactpersonen
Meer over: Mojonnierkolf rond reservoir vlg DIN, l=187mm, Ø hals 13mm
Eigenschappen